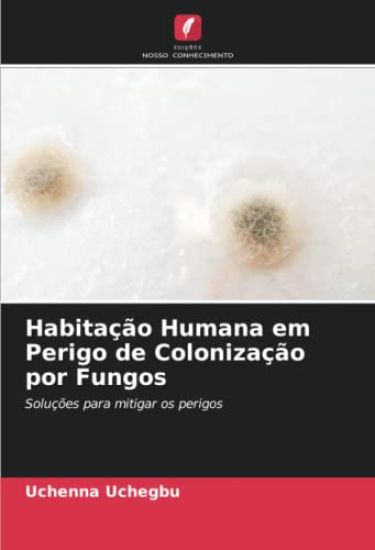
Habitação Humana em Perigo de Colonização por Fungos
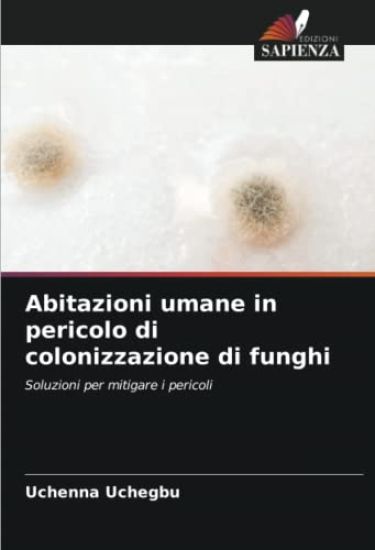
Abitazioni umane in pericolo di colonizzazione di funghi

Chelowecheskoe zhil'e w opasnosti gribkowoj kolonizacii
Uchenna Uchegbu · ISBN 9786204549507
Julkaistu 2022 Kieli venäjä nidottu
161 tulosta hakusanalla Uchenna Uchegbu.

Uchenna Uchegbu · ISBN 9786204549507
Julkaistu 2022 Kieli venäjä nidottu

Uchenna Uchegbu · ISBN 9786204549514
Julkaistu 2022 Kieli saksa nidottu

Uchenna Uchegbu · ISBN 9786204549521
Julkaistu 2022 Kieli espanja nidottu

Uchenna Uchegbu · ISBN 9786204549538
Julkaistu 2022 Kieli Ranska nidottu
Uchenna Uchegbu · ISBN 9786204549545
Julkaistu 2022 Kieli portugali nidottu
Uchenna Uchegbu · ISBN 9786204549552
Julkaistu 2022 Kieli italia nidottu

Uchenna Uchegbu · ISBN 9786204740379
Julkaistu 2022 Kieli englanti nidottu
Public deliberation, highly valued by many African societies, becomes the cornerstone of a new system of African political philosophy in this brilliant, highly original study. I...
Public deliberation, highly valued by many African societies, becomes the cornerstone of a new system of African political philosophy in this brilliant, highly original study. I...

Uchenna B. Okeja · ISBN 9780739176900
Julkaistu 2012 Kieli englanti sidottu
The focus of this book is the normativity of global ethic. Over the years, different cultures and civilizations have been brought closer than never before by globalization. This...

UCHENNA AKWARA · ISBN 9781365590719
Julkaistu 2016 Kieli englanti nidottu
In robotic world, series of invention and innovation are at the highest peak of breaking even. In this book, hybrid histogram in-motion model (HHIM) for autonomous mobile robot...
It's easy to walk past the homeless, to disregard the guy lying on the street or ignore the woman standing at an intersection holding a handwritten sign with a plea for help. It...

Uchenna Odogwo · ISBN 9781435703759
Julkaistu 2007 Kieli englanti pokkari
Historical accounts of polictical events in Nigeria pertaining to military and civilian rule.

Uchenna Facog Nwosu · ISBN 9781441590268
Julkaistu 2009 Kieli Multi - monikielinen pokkari

Uchenna Facog Nwosu · ISBN 9781441590275
Julkaistu 2009 Kieli Multi - monikielinen sidottu

Uchenna S. Ani · ISBN 9781494332457
Julkaistu 2013 Kieli englanti nidottu

Uchenna S. Ani · ISBN 9781494408978
Julkaistu 2013 Kieli englanti nidottu